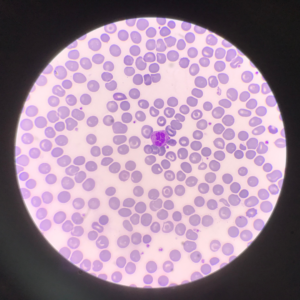
A picture of cells in a purple shade under a microscope - represented in an article about gene and cell therapy for the future of rare disease

Cell & Gene Therapy: The Future of Rare Disease
For decades, rare diseases were defined by what they lacked: effective treatments, sustained funding, widespread awareness, and long-term outcome data.
When I began my career as a nurse working in the emergency department in the late 1990s, this reality was something we saw in patients’ lives every day. Many genetic and rare conditions carried prognoses that were heavy and felt almost predetermined. For diseases like cystic fibrosis or hemophilia, treatment options were limited, and survival into adulthood was far less common than it is today.
lives every day. Many genetic and rare conditions carried prognoses that were heavy and felt almost predetermined. For diseases like cystic fibrosis or hemophilia, treatment options were limited, and survival into adulthood was far less common than it is today.
In 2001, I encountered this reality in a deeply personal way. During a time when cystic fibrosis carrier screening was only beginning to expand in parts of the United States, I learned that I was a carrier of the disease. Screening practices varied widely by state and clinical setting, and public understanding of genetic carrier status was still evolving.
Those experiences, both professional and personal, shaped how I think about rare diseases today.
The landscape has changed dramatically since then. Scientific advances, including enzyme replacement therapies, biologics, and now cell and gene therapies, have transformed what is possible for individuals living with rare and complex diseases.
But that progress has introduced a new and less frequently discussed challenge.
People with rare diseases are living longer than ever before, and our healthcare systems are still learning how to support that reality.
Rapid Innovation in Rare and Immune-Mediated Disease
There have been a few meetings already this year convening stakeholders in the rare disease communities. The conversations across these meetings reinforced just how quickly the scientific landscape is evolving.
At WORLDSymposium, discussions across Gaucher, Fabry, Pompe and MPS communities highlighted the accelerating pace of advancement in lysosomal storage disorders and other ultra-rare genetic diseases. Many conversations are shifting from managing symptoms to therapies that may fundamentally alter the course of disease.
Several trends were clear across rare disease communities:
· Expansion of cell and gene therapy pipelines
· Earlier diagnosis through newborn screening and genetic testing
· Increasing global collaboration in clinical trials
· Growing complexity in access to treatments
Gene therapy for rare diseases is evolving from theoretical promises to clinical reality. For some individuals, the possibility of altering their disease progression represents a profound shift in what medicine can offer. Yet across many of these conversations, one concern surfaced repeatedly: the pace of scientific progress is accelerating faster than the systems designed to support patients.
Diagnostic pathways, insurance navigation, treatment logistics, and long-term follow-up care are still catching up to what science is now making possible.
At the American Academy of Allergy, Asthma & Immunology (AAAAI) Annual Meeting, the biology shifts, yet the structural challenges feel strikingly familiar. Primary immune deficiency, autoimmune, and inflammatory diseases are increasingly being managed with biologics and precision therapies. We are improving survivorship, but the complexity of care is rising.
It seems that precision medicine does not automatically simplify coverage decisions, logistics of infusion and specialty pharmacy coordination, or out of pocket costs.
Cell and Gene Therapy: Promise Meets Reality
Cell and gene therapies represent one of the most transformative developments in rare disease care in decades. For many conditions, they offer the possibility of stabilizing or even altering disease progression in ways that were once unimaginable. And for families who have spent years navigating progressive illness, these therapies represent something rare: the possibility of rewriting the trajectory of disease, rather than managing its symptoms.
But that promise comes with a new level of complexity.
Unlike traditional medications, many cell and gene therapies require highly specialized treatment centers, intense monitoring, and a still-evolving reimbursement model. The coordination of even accessing treatments can be daunting.
Several challenges that are becoming increasingly clear:
· High upfront costs and evolving or unclear payment frameworks
· Limited treatment centers with that specialized expertise
· Travel and geographical barriers to care
· Uncertainty around long-term outcomes
This innovation brings both hope and anxiety. The emotional weight of life-altering treatment decisions becomes compounded by the realities of accessing care.
As of today, there are dozens of approved gene therapies globally, with hundreds more in development pipelines. As rare disease therapies advance toward broader adoption and approval, we can start to see how scientific innovation alone is not enough.
Aging With Rare and Immune-Mediated Disease
 One of the most under-recognized shifts in rare and immune-mediated disease care is aging. Historically, many rare, genetic, and immune conditions limited a person’s survival to adulthood. However, advances in biologics, enzyme replacement therapies, immune modulation, and emerging gene-based treatments have changed that trajectory. Increasingly, individuals who once faced childhood mortality are now living well into adulthood. In conditions such as cystic fibrosis, median predicted survival now exceeds 50 years in the United States, reflecting a dramatic shift in long-term outcomes
One of the most under-recognized shifts in rare and immune-mediated disease care is aging. Historically, many rare, genetic, and immune conditions limited a person’s survival to adulthood. However, advances in biologics, enzyme replacement therapies, immune modulation, and emerging gene-based treatments have changed that trajectory. Increasingly, individuals who once faced childhood mortality are now living well into adulthood. In conditions such as cystic fibrosis, median predicted survival now exceeds 50 years in the United States, reflecting a dramatic shift in long-term outcomes
This progress is a remarkable achievement for modern medicine. But it also introduces questions that healthcare systems are only beginning to confront.
What does aging look like in bodies shaped by lifelong rare or immune-mediated disease? How do neurological, cardiovascular, metabolic, and musculoskeletal systems evolve over many years when historical conditions had previously limited long-term survival? How should adult care systems adapt with data developed in pediatric cohorts?
In most cases, longitudinal data simply does not exist yet. We are learning, in real time, how these diseases progress across a full lifespan and how care models must evolve to support aging populations.
Rare disease is no longer solely a pediatric story. It is increasingly a lifelong story, one that requires healthcare systems, policy structures, and support organizations to evolve as they do.
Why Policy and Advocacy Matter
As therapies become more advanced, including cell and gene therapies, the role of policy and advocacy becomes even more critical in determining how advancements translate into access.
These challenges are not confined to clinical settings. They increasingly intersect with policy decisions that ultimately shape how new therapies are delivered, covered, and sustained across health systems.
This is why policy-focused events, such as NIH rare disease day, and legislative engagement on Capitol Hill remain so important. When my colleague Tiara Green participated in these discussions earlier this year, she noted the strong presence of researchers, clinicians and advocates working together to better understand how to address the barriers that people are facing when trying to access these emerging therapies.
Organizations like the National Health Council play a critical role in helping patient-focused organizations remain informed and engaged in this rapidly evolving policy environment. Through their government affairs work they help ensure that the voices of patients remain part of the conversations shaping healthcare policy.
Advocacy in rare diseases often extends well beyond formal professional roles. Longtime healthcare attorney and policy expert William Sarraille recently shared publicly that he is living with a rare disease that currently has no available treatment. After many years spent advising healthcare organizations and shaping conversations around patient access, his willingness to speak openly about his own diagnosis serves as a powerful reminder that rare disease advocacy is deeply personal and often continues long after professional titles evolve.
Stories like William’s reinforce why sustained collaboration across clinicians, policymakers, and advocacy organizations, particularly as the healthcare system works to keep pace with rapidly advancing therapeutic innovation.
Where Accessia Health Fits In
At Accessia Health, we focus on helping individuals access, afford, and navigate care as the treatment landscape grows more complex. This includes helping individuals pay for their screening and diagnostics testing, clinical trials, medication copays, travel, and more.
And as healthcare science continues to accelerate, it will be even more important for people to have holistic support available. That includes offering comprehensive programming and financial assistance that goes beyond medication copays to provide individualized help where people need it most.
Looking Ahead
Rare and complex disease care is entering a new era. Scientific advances are helping people live longer than ever before. But longer lives bring new questions about long-term outcomes, aging, and what it means to truly live well with a rare condition.
Science has moved quickly. Now the challenge is ensuring the support systems keep pace.
written by: Jennifer Noonan, VP of Clinical Strategy










